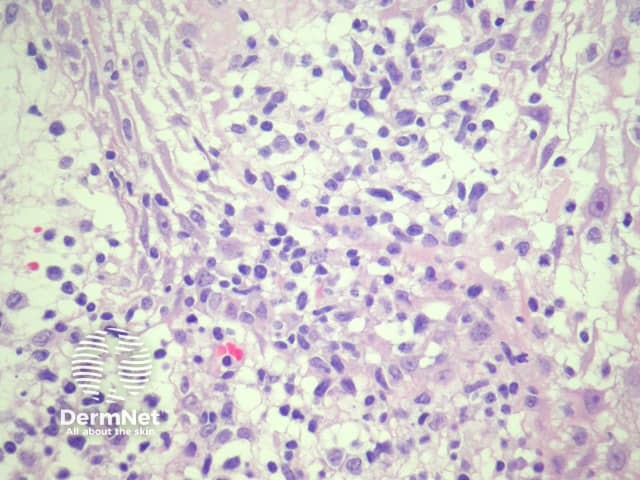
Figure 2
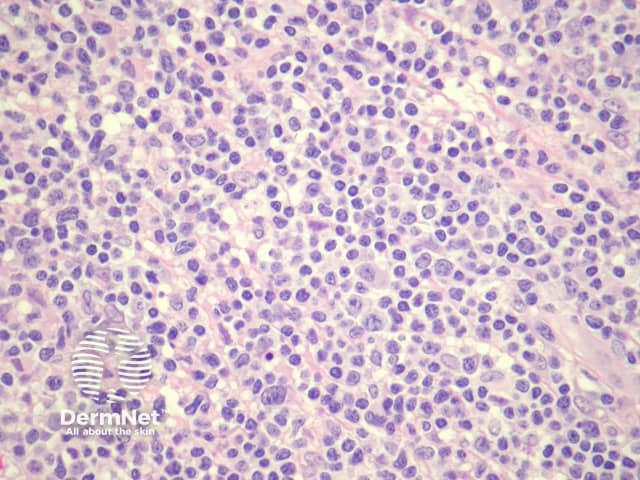
Figure 4

Main menu
Common skin conditions
NEWS
Join DermNet PRO
Read more
Quick links
Lesions (cancerous) Diagnosis and testing
Author: A/Prof Patrick Emanuel, Dermatopathologist, Auckland, New Zealand, 2014.
Introduction
Histology
Special studies
Differential diagnoses
Cutaneous small–medium pleomorphic T-cell lymphoma is a recently described form of cutaneous lymphoma, which typically presents as a solitary tumour on the head/neck or trunk in elderly patients. Some authorities regard this entity as a form of pseudolymphoma owing to its indolent clinical course.
In cutaneous small–medium pleomorphic T-cell lymphoma, sections show a dense lymphoid infiltrate (figure 1), often with infiltration of the overlying epidermis (figure 2). The infiltrate is composed of small and medium sized lymphocytes which exhibit quite marked pleomorphism. There are few admixed larger cells (figures 3, 4, 5). In some cases there may be a surrounding reactive population of other inflammatory cells which can cause diagnostic confusion.

Figure 1
Figure 2

Figure 3
Figure 4

Figure 5
The infiltrate is composed primarily of CD4-positive T cells (figure 6). CD8-positive T cells are far few in number (figure 7). There is often loss of T-cell markers such as CD5 and CD7. CD20 highlights fewer reactive B cells.
T-cell receptor gene rearrangement may be demonstrated with rearrangement studies.

Figure 6

Figure 7
Mycosis fungoides: clinical presentation is key in distinguishing this entity from tumour stage mycosis fungoides. If the patient has a past history of mycosis fungoides, caution should be take in diagnosing cutaneous small-medium pleomorphic T-cell lymphoma.
T-cell pseudolymphoma: may be similar and many cases may have been called pseudolymphoma in the past. Immunohistochemical studies and T-cell gene rearrangement studies may be helpful to illustrate a clonal population.
Peripheral T-cell lymphoma, not otherwise specified: This diagnosis must be excluded by way of clinical correlation as the prognosis is clearly far worse for a peripheral T-cell lymphoma.
Cutaneous B-cell lymphoma: When numerous reactive B cells are present in the infiltrate the lesion can mimic a B-cell lymphoma. Gene rearrangement and other immunohistochemical studies are usually needed.